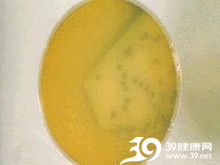

革兰阴性杆菌感染简介:革兰阴性杆菌是引起人类感染性疾病的主要病原之一。在感染性疾病的病原构成中占有重要的地位,同时,革兰阴性杆菌对临床常用抗菌药物耐药性日益严重,其中产超广谱β-内酰胺酶的革兰阴性杆菌在临床上分离率高,所致感染治疗困难,是当前最受关注的耐药菌。
症状起因
症状起因:
革兰阴性菌感染 常见有脑膜炎球菌,痢疾、伤寒、副伤寒、沙门、肉毒杆菌等,与医院内感染中常见的大肠、克雷白、变形、绿脓杆菌以及其他少见的军团病菌和淋球菌等。
就诊指南
就诊指南:
革兰阴性杆菌感染就诊指南针对革兰阴性杆菌感染患者去医院就诊时常出现的疑问进行解答,例如:革兰阴性杆菌感染挂什么科室的号?革兰阴性杆菌感染可能患上什么疾病?与革兰阴性杆菌感染容易混淆的症状?医生一般会问什么?等等。革兰阴性杆菌感染就诊指南旨在方便革兰阴性杆菌感染患者就医,解决革兰阴性杆菌感染患者就诊时的疑惑问题。
- 建议就诊科室
- 内科
- 相关检查
- 1、血清淋球菌抗体,淋球菌抗体检测是用淋球菌抗原固相硝酸纤维素膜,应用渗滤式间接法原理,检测血清中淋球菌抗体。
- 2、脓汁和创伤感染标本细菌学检查,脓汁和创伤感染标本细菌学检查用于病原菌的诊断,为感染治疗提供依据。
↑ UP







